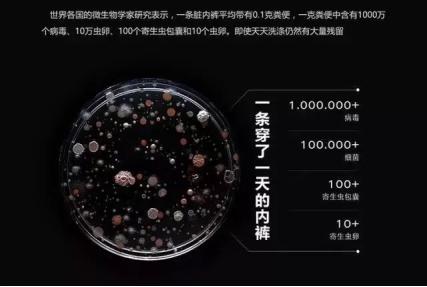
​美丽防护，别忘了“私密处”的小防护！

2020年的开端很艰难,朋友聚不得,美景看不得,美食吃不得……出门买菜回家,即使带了两层口罩,也总觉得不安全。
也许到了这时候,我们才知道最重要的是健康。
没有健康,一切都是无稽之谈,有个好身体,是做一切事情的前提。
新年伊始,逼自己健康一点。
作为一名女性,柔粉们,有多少真正关心过自己*裤内**的健康卫生。
*裤内**是女人最贴身的衣物,*裤内**不仅与女人的美丽有关,更与女性*处私**的健康息息相关。*裤内**作为我们最贴近私密处的衣物,不仅是保护我们*处私**的最后一道防线,还肩负着防止分泌物沾染到外衣的使命。
但由于其私密性,我们常常羞于提及。
因此一些相关的健康问题和隐患,往往会被我们所忽视。
对洗衣机研究的微生物学家早就说出了答案,据微生物学家研究的数据显示,平均每条旧*裤内**上带有0.1g粪便,而粪便中带有沙门氏菌、大肠杆菌等。所以,*裤内**干不干净,直接影响到生殖器健康,特别是女性,更容易因为*裤内**发生阴道炎、阴道异味、*处私**湿疹等,长期受到此类妇科疾病的干扰,会破坏我们人体免疫系统的防线。

在选购*裤内**的时候,一定要了解好材料,之后再进行选择,不要看可爱性感哟,想要*处私**一直保持健康的话,建议选择使用经过检验,健康、透气的安全布料。*裤内**的选择,要慎选!别让*裤内**影响您下半身的健康。

柔漾品牌负离子绵柔*裤内**布料符合酸碱值检验,不含荧光剂,环保科技染色,一等品,服帖舒适,亲肤的陪伴为舒适而来,畅享来自细腻的触感,享瘦每个自在日常,自由弹力蕾丝边,唤醒与生俱来的优雅气息,用心精选良材,柔软,亲肤,吸湿,透气。

抑菌内档:档部使用毛巾皱褶式设计,透气干爽,防臭,可改善女性恼人的分泌 物及潮湿搔痒等问题。
进口原材料:高科技一体成型编织,含天然植物纤维,环保健康,布料蛋型多孔设计舒适透气。
臀部立体杯型设计:全包提臀不变形,包臀不移位,提臀不夹裆,高弹力裤腰,24小时穿着,享瘦。

最后,小柔想说:
现在这个时刻,我们保护好自己,就是为社会和国家做贡献!
日常的清洁卫生做好,才能保证我们私密处的健康啊~记得*裤内**一定要做到及时更换,再强调一下,再穷也不能穷*裤内**!